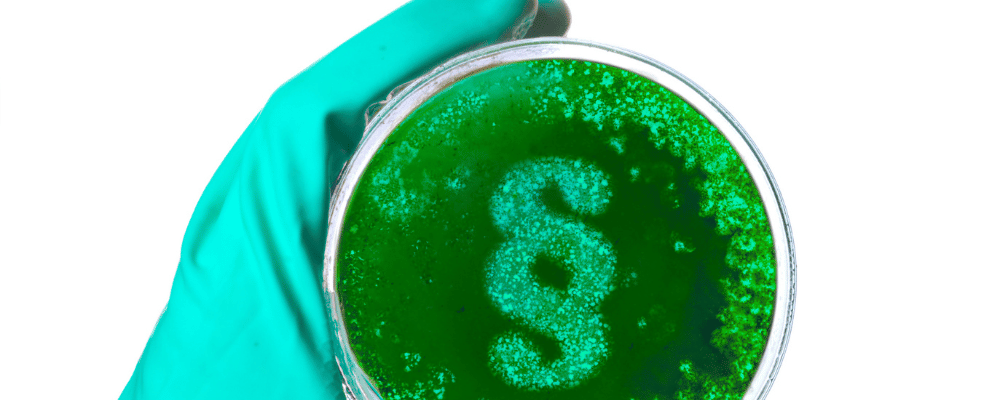
Hand im Handschuh mit Petrischale

Schulen sind durch das Zusammenleben und die Zusammenarbeit einer Vielzahl von Personen von besonderer hygienisch-epidemiologischer Bedeutung. Sie bedürfen deshalb großer Aufmerksamkeit, um das Wohlbefinden, die Gesundheit und die Erziehung zu hygienischem Verhalten – besonders auch im Hinblick auf Infektionskrankheiten – zu sichern.
Das Infektionsschutzgesetz (IfSG) regelt, welche Krankheiten bei
Verdacht, Erkrankung oder Tod und welche labordiagnostischen Nachweise von Erregern meldepflichtig sind. Weiterhin legt es fest, welche
Angaben von den Meldepflichtigen gemacht werden und welche dieser Angaben vom Gesundheitsamt weiter übermittelt werden.
Zusätzlich werden die Meldewege dargestellt.